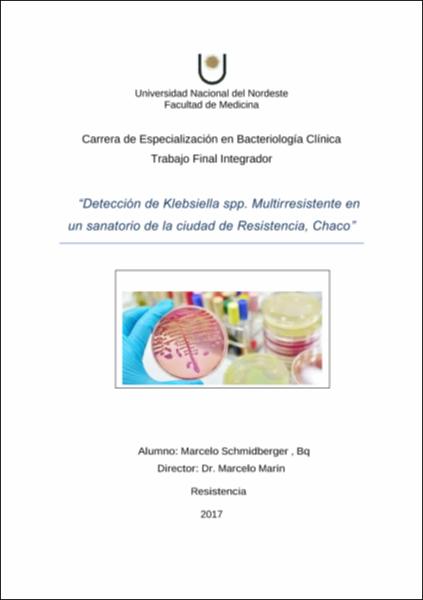
Thumbnail

Trabajos de especialización
Envíos recientes
-
Análisis de los casos bacteriológicamente confirmados de tuberculosis durante el periodo 2014-2015 en el laboratorio central de la provincia de Chaco
(Universidad Nacional del Nordeste. Facultad de Medicina, 2017)Una comprensión cabal del agente etiológico, de la presentación clínica y de la epidemiología de la tuberculosis, así como de la manera de aplicar eficazmente las herramientas disponibles actualmente para su control, pueden ... -
Staphylococcus coagulasa positivos aislados de caninos. Caracterización fenotípica y perfiles de resistencia a antimicrobianos
(Universidad Nacional del Nordeste. Facultad de Medicina, 2014)Los Staphylococcus están ampliamente difundidos en la naturaleza. Su hábitat natural es la piel y las membranas mucosas de mamíferos y aves. No obstante, la difusión de cepas de Staphylococcus sp. entre diferentes especies ... -
Prevalencia de colonización por Streptococcus agalactiae en embarazadas entre 35 y 37 semanas de gestación en pacientes del laboratorio regional de bacteriología, Machagai
(Universidad Nacional del Nordeste. Facultad de Medicina, 2018)Streptococcus agalactiae o Streptococcus ß-hemolítico del Grupo B (SGB) es una bacteria Gram positiva, anaeróbica facultativa, catalasa y oxidasa negativa, que se presenta formando cadenas de longitud variable y vive de ... -
Estudio exploratorio de la portación de Staphylococcus aureus meticilino resistente en perros y su relación con infecciones en personas de su entorno en la ciudad de Curuzú Cuatiá
(Universidad Nacional del Nordeste. Facultad de Medicina, 2014)Los miembros del género Staphylococcus se encuentran entre las bacterias no esporuladas más resistentes y pueden sobrevivir en condiciones ambientales no fisiológicas. Siendo Staphylococcus aureus un patógeno oportunista ... -
Infecciones por bacilos gram negativos no fermentadores en una unidad de terapia intensiva para adultos
(Universidad Nacional del Nordeste. Facultad de Medicina, 2014)Los bacilos gram negativos no fermentadores (BNNF) son un grupo heterogéneo de microorganismos que no utilizan los hidratos de carbono como fuente de energía o los degradan a través de vías metabólicas diferentes de la ... -
Detección de Klebsiella spp. Multirresistente en un sanatorio de la ciudad de Resistencia, Chaco
(Universidad Nacional del Nordeste. Facultad de Medicina, 2017)Los microorganismos del género Klebsiella son bacilos gramnegativos inmóviles, anaerobios facultativos que pertenecen a la familia Enterobacteriaceae. La capa más externa de Klebsiella spp. está formada por una gran ... -
Detección de cepas productoras de Carbapenemasas KPC en enterobacterias en el Hospital San Bernardo de Salta
(Facultad de Medicina, 2018)La familia Enterobacteriaceae está constituida por un grupo heterogéneo y numeroso de bacterias gram negativas que se localizan habitualmente como saprófitos en el tubo digestivo de humanos y animales, aunque pueden ... -
Resistencia antimicrobiana de E. coli aisladas de urocultivos en pacientes ambulatorios
(Universidad Nacional del Nordeste. Facultad de Medicina, 2016)Entre todas las infecciones humanas, las del aparato urinario son una de las más frecuentes, ocupando el segundo lugar después de las respiratorias. Excepto algunos microorganismos que se pueden encontrar en la ... -
Estudio del perfil de células no habituales en el contenido vaginal definidos según BACOVA, asociadas con los estados vaginales básicos y la trichomonas vaginalis / levaduras y otros agentes microbianos
(Universidad Nacional del Nordeste. Facultad de Medicina, 2016)El Balance del Contenido Vaginal (BACOVA) genera el nuevo concepto de determinación de Estados Vaginales Básicos (EVBs), que define con un alto valor predictivo el estado funcional vaginal de toda mujer estudiada (1). ... -
Campylobacter jejuni en pacientes con cuadros diarreicos agudos que acuden al Hospital de Clínicas-San Lorenzo. Paraguay, en el periodo marzo del 2013 a marzo del 2014
(Facultad de Medicina, 2014)La Campilobacteriosis es una enfermedad gastrointestinal preferentemente producida por agentes bacterianos del género Campylobacter sp. Este género está constituido por bacilos gramnegativos pequeños, con forma de coma o ... -
Frecuencia de aislamiento de gérmenes comunes en semen y su relación con la calidad espermática en pacientes con problemas de infertilidad
(Universidad Nacional del Nordeste. Facultad de Medicina, 2016)El diagnóstico exacto de la causa de infertilidad es el resultado de un proceso pluridisciplinar, pudiendo recurrir a numerosos exámenes complementarios de distinta complejidad. Es muy importante, ya que condiciona la ... -
Portación nasal de Staphylococcus spp. Resistentes a Meticilina en internos del Servicio Penitenciario N° 3 de Villa Ángela Chaco
(Universidad Nacional del Nordeste. Facultad de Medicina, 2017)La portación nasal de especies de Staphylococcus meticilino resistentes (SMR) es considerada un factor de riesgo para infecciones de piel y partes blandas. La autoinoculación y la transmisión horizontal de persona a ... -
Evolución de la susceptibilidad a antimicrobianos de staphylococcus aureus en el Hospital 4 de junio “Dr. Ramón Carrillo” de Presidencia Roque Sáenz Peña- Chaco- durante una década (2003-2013)
(Universidad Nacional del Nordeste. Facultad de Medicina, 2014)Los estafilococos son cocos gram positivos miembros de la familia Micrococcaceae que aparecen en racimos irregulares en forma de uva, tétradas, cadenas cortas (tres o cuatro células) y pares, o como células individuales. ... -
Gestión de bioseguridad en el laboratorio de análisis clínicos y microbiológicos: diagnóstico de situación
(Facultad de Medicina, 2017)El estudio de los agentes infecciosos y la manipulación de material biológico conllevan a riesgos que varían según el agente infeccioso, el tipo de material y los procedimientos utilizados. Tiende a asumirse erróneamente ... -
Interacción in vitro entre cotrimoxazol y norfloxacina en bacterias uropatógenas
(Facultad de Medicina, 2014)Los antimicrobianos son sustancias naturales o sintéticas cuya función es inhibir el crecimiento o destruir a la célula bacteriana. Hay una amplia diversidad de familias y grupos de antimicrobianos de interés en medicina ... -
Colonización y perfil de resistencia de streptococcus agalactiae en gestantes del Hospital Regional de Encarnación
(Universidad Nacional del Nordeste. Facultad de Medicina, 2014)El Estreptococo Beta-Hemolítico del Grupo B (SGB) o Streptococcus agalactiae es uno de los principales agentes causantes de sepsis neonatal precoz. Puede encontrarse, según la literatura internacional, como colonizante ... -
Frecuencia de Staphylococcus aureus meticilino resistente y del factor de virulencia LPV en pacientes ambulatorios que concurren al Instituto de Investigaciones en Ciencias de la Salud y al Sanatorio San Roque de la cuidad de Asunción
(Universidad Nacional del Nordeste. Facultad de Medicina, 2015)El Staphylococcus aureus (S. aureus) representa uno de los principales patógenos de importancia clínica en el humano, su distribución es mundial y el impacto en la morbilidad y mortalidad es considerable no solamente en ...